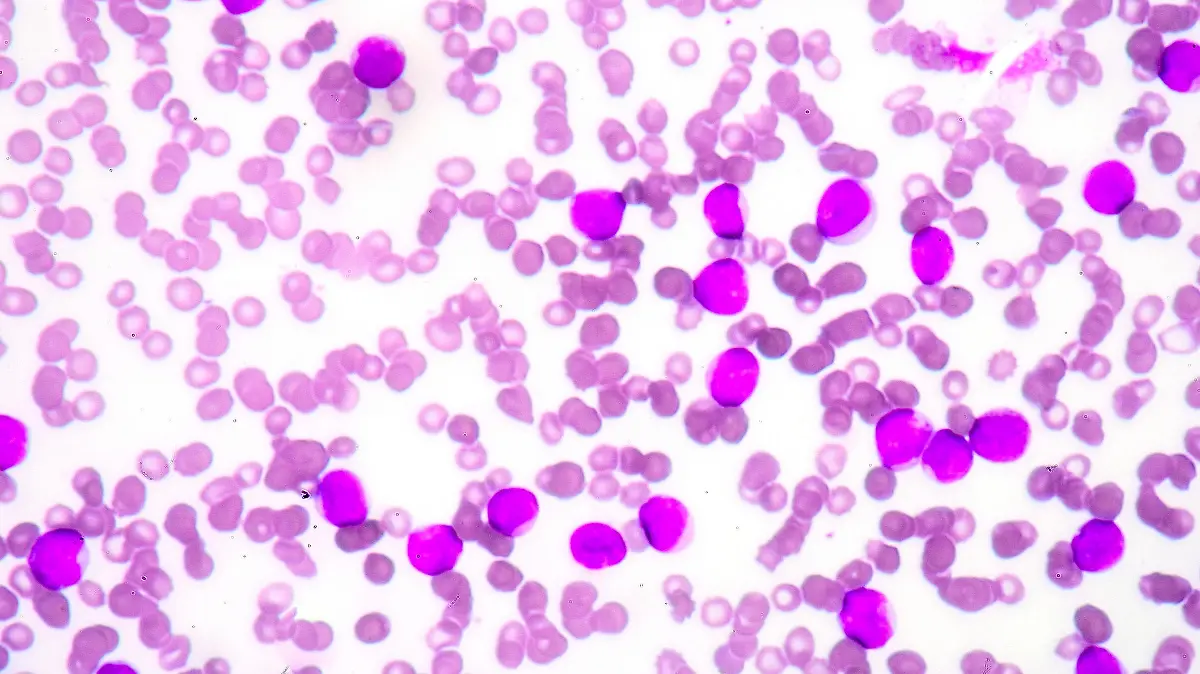

Schockdiagnose für Laura bei GZSZSeltene Knochenmarksstörung: Was ist Aplastische Anämie?
Für GZSZ-Star Laura (Chryssanthi Kavazi) stellt eine Diagnose das Leben komplett auf den Kopf: Sie hat Aplastische Anämie (AA). Für den neuen Handlungsstrang bei „Gute Zeiten, schlechte Zeiten“ hat das Serienteam eng mit der DKMS zusammengearbeitet:
Aber was versteckt sich hinter der Krankheit eigentlich und was kommt auf Patienten zu, bei denen eine Aplastische Anämie diagnostiziert wurde.
Was ist Aplastische Anämie?
Als Aplastische Anämie (auch aplastisches Syndrom, Panmyelopathie oder Panmyelophthise genannt) bezeichnet man eine seltene Sonderform der Blutarmut (dafür steht „Anämie“). Bei dieser liegt eine Störung der Knochenmarksfunktion, eine sogenannte Panzytopenie, vor, durch die alle Zellen des Blutes nur noch in verringerter Anzahl vorkommen. Es treffen also eine Anämie (weniger Hämoglobin), eine Leukopenie (weniger Leukozyten) und eine Thrombozytopenie (weniger Thrombozyten) aufeinander. Von einer Aplastischen Anämie spricht man bei einem Zellgehalt im Knochenmark von unter 25 Prozent.

Was sind die Ursachen für AA?
In einigen wenigen Fällen ist die AA angeboren, meist wird sie jedoch erst im Laufe des Lebens erworben, wie beispielsweise bei Laura in GZSZ. Warum manche Menschen irgendwann an aplastischer Anämie erkranken, ist in rund 70 Prozent der Fällen unbekannt. In den anderen Fällen sind Medikamente (wie nicht-steroidale Antiphlogistica oder Antirheumatika, Chloramphenicol, Penicillamin, Allopurinol, Thyreostatika u. a.), Giftstoffe (wie Benzol, Pentachlorphenol/PCP und Arsenverbindungen) ionisierende Strahlung oder Viren (wie Parvovirus B19 und Epstein-Barr-Virus) schuld.
Aplastische Anämie: Symptome und Behandlung
Eine Aplastische Anämie geht mit mehreren Symptomen einher, die auch auf viele andere Krankheiten hinweisen können. Darunter zum Beispiel Kopfschmerzen, Übelkeit, Leistungsschwäche, Gewichtsabnahme, Müdigkeit und Schwindel bis hin zur Ohnmacht. Wegen der Panzytopenie sind Menschen mit AA häufig sehr blass und anfällig für verschiedene Infektionen. Sie bekommen schnell blaue Flecken und Frauen haben eine verlängerte Menstruation.
Die Diagnose bringt jedoch erst eine Laboruntersuchung des Bluts.
Ist eine Stammzelltransplantation notwendig?
Wie eine Aplastische Anämie behandelt wird, richtet sich nach dem Schweregrad der Erkrankung. Bei der leichten Form (MAA: moderate aplastic anemia) kann man abwarten, ob die Symptome dem Patienten schwer zu schaffen machen. Häufig können Menschen mit dieser Form gut leben. Bei der schweren (SAA: severe aplastic anemia) oder sehr schweren (VSAA: very severe aplastic anemia) Form reichen die Behandlungsmaßnahmen von Bluttransfusionen über eine immunsuppressive Therapie (IST), also eine Behandlung mit Medikamenten, die die Funktion des Immunsystems beeinflussen, bis hin zur Blutstammzelltransplantation.
Werden Sie Stammzellspender!
Mit dem Handlungsstrang rund um Lauras Erkrankung will GZSZ in Zusammenarbeit mit der DKMS auf die Wichtigkeit hinweisen, sich als Stammzellspender zu registrieren. Alles darüber, wie Sie Spender werden und somit vielleicht Leben retten können, erfahren Sie hier!


